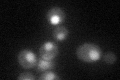
YOL093W
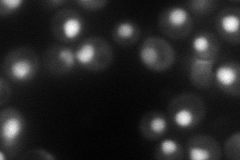
YOL093W
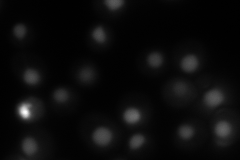
YOL093W
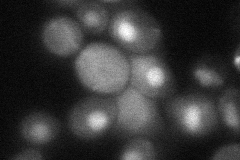
YOL093W
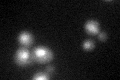
YOL093W

View description
tRNA methyltransferase, methylates the N-1 position of guanosine in tRNAs
Localization:
Intensity:
Fold change:
Significance:
-
C’ GFP library in SD
nucleus34.9 -
N' NOP1pr-GFP in SD
nucleus90.1219 -
N' TEF2pr-mCherry in SD
nucleus126.875 -
N' NATIVEpr-GFP in SD

nucleus32.2283 -
N' TEF2pr-VC and Cyto-VN in SD
nucleus49.735 -
C’ GFP library in SD+DTT
nucleus28.810.82No -
C’ GFP library in SD+H2O2

nucleus34.490.98No -
C’ GFP library in Starvation Media

nucleus27.290.78No -
C’ GFP library on the background of Pup2-DaMP

nucleus -
C’ GFP library on the background of CCT mutant

nucleus33.22670.951726No
